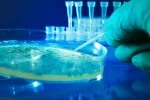
Causas de la cistitis

Qué es la cistitis

Bióloga
Por: Dr. José Antonio Nuevo González
Especialista en Medicina Interna. Servicio de Urgencias del Hospital Gregorio Marañón de Madrid
Actualizado: 21 de septiembre de 2022
La cistitis es una infección de la parte baja del tracto urinario, en concreto de la vejiga, que es causada por bacterias. En muchas ocasiones se la conoce como infección urinaria. La presencia de síntomas diferencia a la cistitis de la bacteriuria asintomática; esta última implica solo presencia de bacterias en un análisis de orina, pero sin molestias de ningún tipo, y por tanto, no precisa de tratamiento excepto en casos concretos.
En algunas ocasiones pueden aparecer episodios ligados a determinados tratamientos médicos, radioterapia, uso de espermicidas o incluso al hecho de llevar puesto un catéter durante un periodo prolongado. Por lo general se recurre al uso de antibióticos para su tratamiento, y suelen resolverse sin problemas, aunque en ocasiones, si no se abordan a tiempo o de la forma adecuada pueden llegar a aparecer algunas complicaciones más serias como hematuria (presencia de sangre en la orina) o pielonefritis (infección renal).
A quién suele afectar la cistitis
La incidencia de cistitis es mayor en el sexo femenino, debido a que las mujeres tienen la uretra más corta y se encuentra más cerca del ano, lo que permite a las bacterias llegar con facilidad a la apertura de la vagina y, de ahí, hasta la uretra y la vejiga.
Por el contrario, el hombre tiene la uretra más larga, y además la próstata secreta una sustancia con un efecto bactericida, que evita el ascenso espontáneo de los microorganismos. Se estima que entre el 10 y el 20% de las mujeres sufrirán al menos un episodio de cistitis a lo largo de su vida, que serán recurrentes en el 20% de los casos.
La edad de mayor incidencia en la mujer es entre los 20 y los 40 años. En el hombre las cistitis son más frecuentes durante los primeros años de vida, asociadas a la posible existencia de anomalías en el tracto urinario, y a partir de los 50 años debido al incremento, a partir de esta edad, del desarrollo de patologías prostáticas.
Creado: 21 de julio de 2010